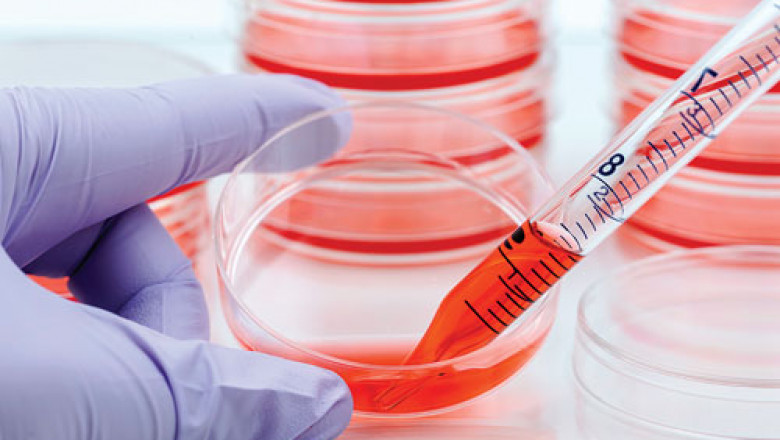

views
Cell culture is one of the most important techniques in cellular and molecular biology, as it provides good model systems for studying cell physiology and biochemistry, pharmacological and toxic chemical effects on cells, as well as mutagenesis and carcinogenesis. It's also employed in drug development and large-scale biological chemical manufacturing. The uniformity and reproducibility of data acquired from a batch of clonal cells are the main advantages of employing cell culture for any of these applications.
The global Cell Culture Market is divided into product types, applications, end users, and geographic regions. Media, serum, and reagent are the most common cell culture consumables. In the previous ten years, the worldwide cell culture market has developed dramatically. Artificial organs and biopharmaceuticals have boosted this industry significantly in the past, and this trend is expected to continue in the coming years. Furthermore, the growing use of cell culture models in drug development is likely to provide a lucrative market for big cell culture players.
Over the forecast period, the worldwide Cell Culture Market is expected to rise due to the rising prevalence of cancer and infectious disorders. The increased need for 3D cell culture for the treatment of various ailments, owing to the rising prevalence of cancer and infectious disorders, is likely to drive market expansion over the forecast period.
According to figures released by the World Health Organization (WHO) in September 2018, cancer is the second biggest cause of death worldwide, accounting for an estimated 9.6 million deaths in 2018. According to the same source, cancer is responsible for around one out of every six fatalities worldwide. Technology advancements such as 3D cell culture Market, organoids, and microfluidics are projected to boost market growth even more. Furthermore, advances in stem cell research and therapy are projected to have a favourable impact on the total cellular growth industry.
Due to its wide range of applications, such as the manufacturing of vaccines, blood and blood components, allergy-treatment proteins, and cells used in various therapies such as cell therapies, gene therapies, and recombinant therapeutic proteins, cell culture media demand is also driving biopharmaceutical production. A cell culture media, also known as growth media, is a solid, liquid, or semisolid medium containing various substances and nutrients that are used to promote the growth, multiplication, maintenance, and storage of microorganisms and plant cells.
Read More:
https://bloggerstrive.blogspot.com/2021/12/cell-culture-market-segment-innovations.html |
https://www.coherentmarketinsights.com/market-insight/cell-culture-market-116 |